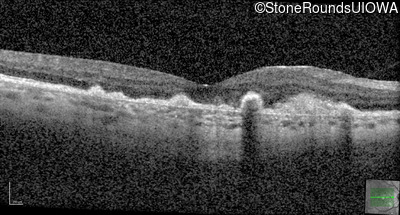
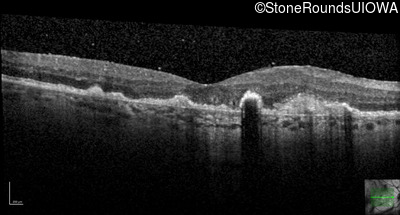
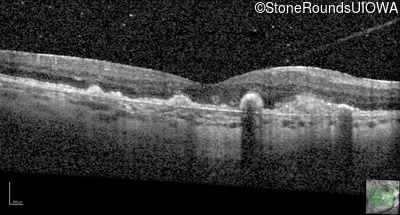
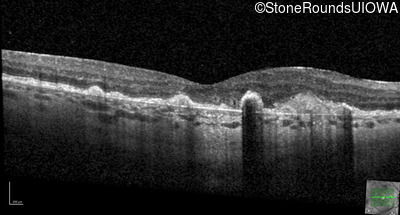
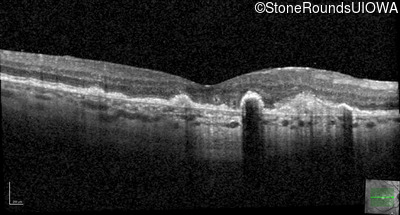
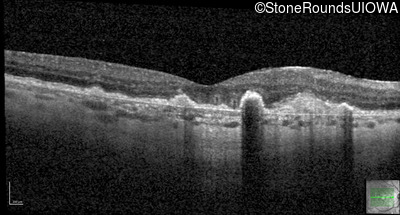
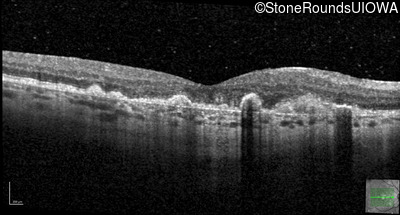
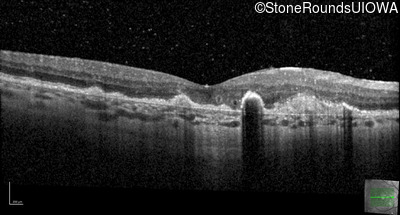
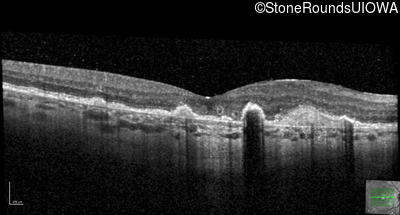
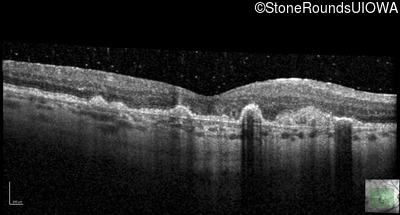
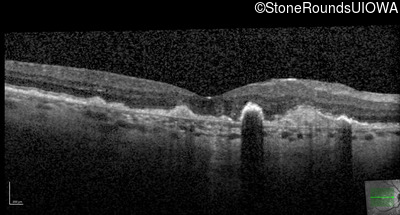
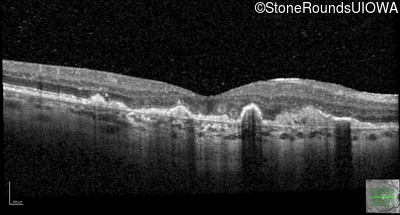
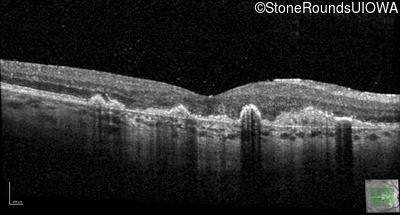
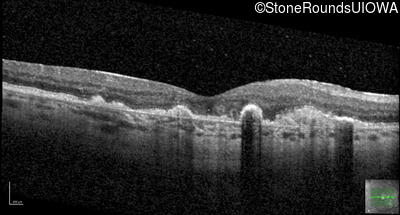
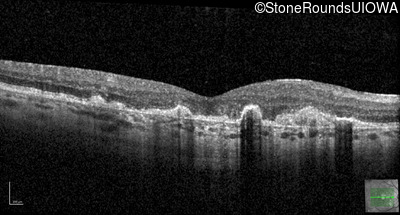
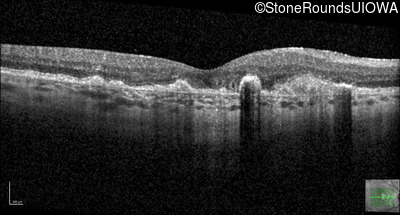
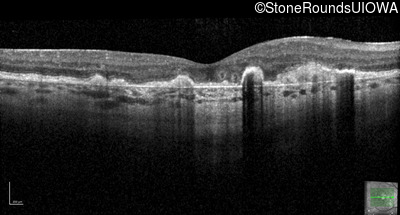
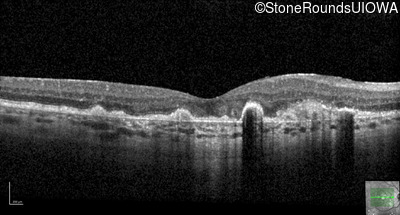

Case
SR29
Student Mode
Malattia Leventinese (IIJ)
Female
Female
Hidden
SR29
Student Mode
Malattia Leventinese (IIJ)
Female
Female
History
This 43 year old woman has experienced a gradual reduction in her central vision for the past 3 years.
| Age at visit: 35 years |
| OD | OS | ||
|---|---|---|---|
Diagnosis & molecular findings
| Disease | Gene | Allele 1 variant(s) | Allele 2 variant(s) | Inheritance mode |
|---|---|---|---|---|
| Malattia Leventinese | EFEMP1 | Arg345Trp CGG>TGG | AD |